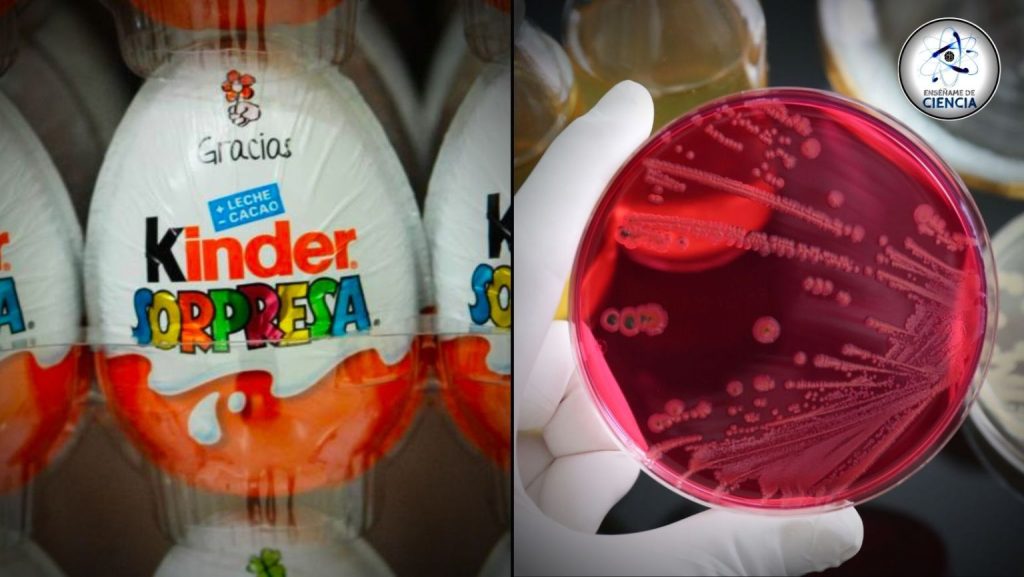

En las últimas horas se ha hecho tendencia a nivel mundial una noticia sobre los famosos huevos “Kinder sorpresa’”, los cuales rápidamente acapararon la atención por una posible contaminación por salmonella en estos productos alimenticios, pero ¿de qué se trata esta infección?
En primer lugar, es conveniente señalar que Salmonella es un género bacteriano que involucra a una amplia gama de bacterias que se pueden alojar en el tubo digestivo de muchos animales, entre ellos los humanos. Cuando este grupo de bacterias logran colonizar los intestinos, se produce un cuadro de infección conocido como “salmonelosis”, la cual, de no atenderse adecuadamente, puede empeorar y provocar la muerte del afectado.
Si bien es cierto que la infección por salmonella suele producirse por el consumo de carnes, aves, huevos o productos a base de huevo que estén crudos o poco cocidos, lo cierto es que también puede ser el caso de consumir productos que se contaminan en la planta donde los proveedores de alimentos distribuyen su contenido (como el reciente caso de la marca Ferrero con su producto Kinder sorpresa).
La salmonelosis muchas veces se describe popularmente como un cuadro diarreico extremo, acompañado de escalofríos y fuertes vómitos. Estos síntomas son los que hacen que esta infección sea muy dolorosa y peligrosa, pues puede llevar a una deshidratación severa que compromete la vida de los afectados.
De acuerdo con la Mayo Clinic, una de las principales instituciones de salud de referencia a nivel mundial, los principales síntomas que caracterizan a la salmonelosis son:
- Náuseas
- Vómitos
- Calambres abdominales
- Diarrea
- Fiebre
- Escalofríos
- Dolor de cabeza
- Sangre en las heces
Mayo Clinic también informa que los signos y síntomas de la infección por salmonela duran de dos a siete días, y que la diarrea puede durar hasta 10 días, aunque pueden pasar varios meses hasta que los intestinos vuelvan a la normalidad.
Las píldoras informativas en materia de salud presentadas en este sitio solo cumplen la función de difusión de lo que ya se ha reportado en la literatura, y dicha información nunca deberá ser usada como método de auto diagnóstico. Si sospecha de alguna enfermedad, consulte a su médico.
Tomado de https://ensedeciencia.com/

Más historias
Frente frío 10 ‘congelará’ este fin de semana; se esperan heladas, lluvias y bajas temperaturas en estas zonas del país
Hermosillo alberga la computadora más poderosa de México: YUCA, el superclúster de la Universidad de Sonora
La olvidada fruta que alivia el estreñimiento y mejora la salud intestinal, según estudios